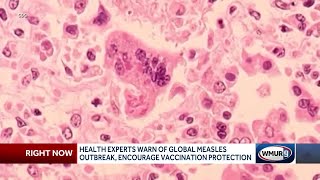

Health experts warn of global increase in measles video
Online izle ve mp4 mp3 formatlarinda yukle
Videonun muddeti: 1:55
Health experts warn of global increase in measles videosu mp4 ve mp3 yuklemek ucun hazirdir
Diqqet! Siz Mp4 yukle ve ya Mp3 yukle duymesine basdiqdan sonra eger sistem sizi reklam sehifesine atarsa o zaman derhal geri qayidib emeliyyati tekrar edin ve faylin yuklemek ucun hazir olmasini gozleyin
Videodan Mp4 Yukle
Videodan Mp3 Yukle-1
Videodan Mp3 Yukle-2
Oxshar Axtarishlar
Health experts warn of global increase in measles
Experts warn of lasting immune effects as measles outbreak spreads
Measles could be a global threat, health officials warn
Measles outbreak and misinformation: What local doctors are saying
Health officials warn on measles outbreak
'Spread like wildfire': Experts warn of measles outbreak if people aren't immunised | Newshub
Researchers warn of millions of U.S. measles cases if shots decline
Measles outbreak spreads as experts warn of lasting immune effects
Health officials warn of potential measles outbreak, encourage parents to get children vaccinated
Video Mp4 Mp3Azwap.Biz
Azwap.Biz 2021-2023